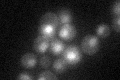
YOL028C
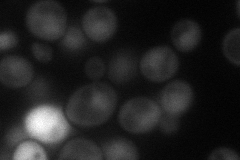
YOL028C
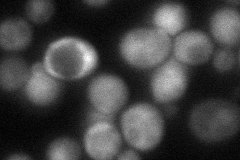
YOL028C
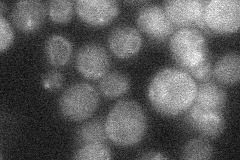
YOL028C

View description
Putative basic leucine zipper (bZIP) transcription factor
Localization:
Intensity:
Fold change:
Significance:
-
C’ GFP library in SD
nucleus25.41 -
N' NOP1pr-GFP in SD
cytosol,nucleus42.8772 -
N' TEF2pr-mCherry in SD
cytosol49.9627 -
N' NATIVEpr-GFP in SD
below threshold19.1998 -
N' TEF2pr-VC and Cyto-VN in SD

below threshold23.4588 -
C’ GFP library in SD+DTT

nucleus19.960.78No -
C’ GFP library in SD+H2O2

nucleus23.440.92No -
C’ GFP library in Starvation Media

nucleus17.80.7Yes -
C’ GFP library on the background of Pup2-DaMP

nucleus -
C’ GFP library on the background of CCT mutant

nucleus22.52010.885933No
